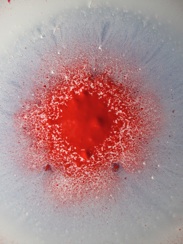

play with colour
a.flitsch

play with colour
a.flitsch
My Photos Photographing Natural PATTENS
12 October 2010

The colour merging is mainly on glass and than photographed as “colour in motion” and the prints are available in A4 & A3 sizes framed or unframed.



























Born in Graz Austria on 10.05.1939.
Interest in visual art began when he started an apprenticeship with a church restorer. Working on concert halls and churches he learned how to use and mix colours.
he than moved to Switzerland where he worked on restoring the outside of wooden chalets and there Ornament on the Facades.
In 1963 he came to Britain and have worked as a painter ever since.
The images he create are with : acrylic paint, Ink, oil, camera, computer, software, print.
The augmentation of those materials are creating multi dimensional almost 3D images which are helped along with fluid and light
All the images are photographed in macro setting , taking the viewer into the fantasy of the Cosmic.












The Magic of colour
<iframe style="width:120px;height:240px;" marginwidth="0" marginheight="0" scrolling="no" frameborder="0" src="//ws-eu.amazon-adsystem.com/widgets/q?ServiceVersion=20070822&OneJS=1&Operation=GetAdHtml&MarketPlace=GB&source=ac&ref=tf_til&ad_type=product_link&tracking_id=wwwplaywithco-21&marketplace=amazon®ion=GB&placement=B00OLZYNIK&asins=B00OLZYNIK&linkId=YTO2AE7NGWD22P4H&show_border=true&link_opens_in_new_window=true">
</iframe>

<iframe src="http://rcm-eu.amazon-adsystem.com/e/cm?t=wwwplaywithco-21&o=2&p=11&l=ur1&category=kindle&banner=1G51MX2X14R3GW0JNJ02&f=ifr" width="120" height="600" scrolling="no" border="0" marginwidth="0" style="border:none;" frameborder="0"></iframe>
Augmentation of oil + water
Observation of Morphin colours
Augmenting colours are morphed into form + structures,
all moving parts have energy.
The principle of movement is change, in a liquid state the solid melts and creates form + patterns, the patterns continually shift and change into biological images.
It is difficult if not impossible to predict the outcome of form and
illustration, but the possibilities are enormous.
Therefore one has to act quick with taking images with camera.
The system will spontaneously tend to take up different structures and forms.
To predict a three dimensional image is impossible, after the image is captured it can be changed in the computer + software
to make it look three dimensional.
Multi Media
Multi Tech.
nihil obstab